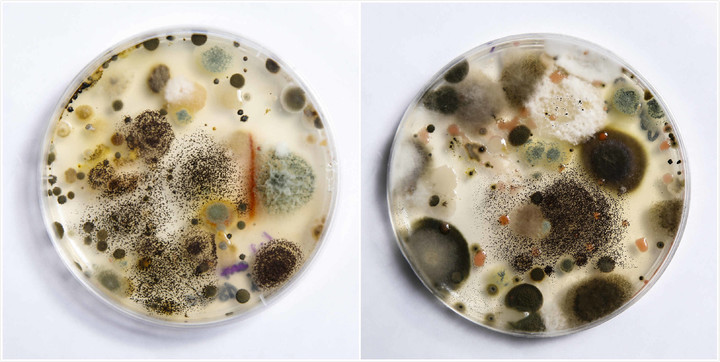

10 万只尘螨在你床上玩得欢,戴森想用这个搭救你
一张床褥内可以住着 10 万至 100 万尘螨。
虽然早有耳闻我们睡的床上布满了尘螨,但戴森工程总监艾德里安诺•尼罗(Adriano Niro)今天在戴森家居灰尘研究发布会上说出这两个数据的时候,我还是吓了一跳。
今年早些时候,戴森团队在中国进行了一个小型研究项目,通过自家的无绳吸尘器在北上广 43 个家庭中收集 3 个地方(地板、床褥以及家具表面)的灰尘样本,分别研究里面的尘螨致敏原和霉菌浓度。我家也是 43 个家庭之一。
戴森将这 43 个家庭样本送往了上海医药临床研究中心,分析结果指出,平均每 1 克的灰尘样本中找到了 58 只尘螨。在最极端的一个样本中,找到了 131 只尘螨。北上广三个城市中,北京室内找到的尘螨最多,平均有 82 只,而上海和广州平均只有 36 只和 21 只。
地板、床褥和家具这三个地方中,床褥是尘螨的重灾区,因为人体的皮屑是尘螨最好的食物。在我家床褥的样本中,每克灰尘平均有 37 只。
事实上,最关键的还不在于这些尘螨的数量,而是它们的排泄物。尘螨排泄物中含有致敏蛋白,戴森的报告中将这些排泄物称之为“尘螨致敏原”。
世界卫生组织的资料显示,致敏原浓度高于 10μg/g(微克/克)就会增加哮喘病发风险。浓度越高,风险越大。在哮喘病之外,尘螨致敏原浓度过高还会导致其他过敏反应,如鼻敏感发作。
报告中指出,中国家庭中每一克灰尘的尘螨致敏原浓度中位数为 18.33μg/g,平均浓度 21.9μg/g。样本中尘螨致敏原浓度最高的一个甚至达 51.75μg/g。而我家床褥上的的美洲室内尘螨致敏原浓度为 11.875μg/g,欧洲室内尘螨致敏原浓度为 10.65μg/g。
和尘螨排泄物同样具有致敏蛋白的还有霉菌。有研究指出,一种霉菌能制造出 40 种以上致敏蛋白,引发的过敏反应有打喷嚏、鼻塞和眼睛发痒等,部分甚至有毒性,对免疫力差的人群有致命风险。
上面提到,每克灰尘中的尘螨只数是北京家庭最多,平均 82 只。而霉菌浓度则是广州最多,中位数为每 1 克灰尘含 264000 cfu(Colony Forming Unit/真菌菌落),而北京和上海则分别为 50859 cfu/g 和 39840 cfu/g。归其原因,位于亚热带气候区的广州有着温暖潮湿的环境,是霉菌的最佳温床。厨房、浴室以及冰箱门密封条这些常年潮湿的地方更是重灾区。
三个城市综合来看,霉菌浓度中位数为 71146 cfu/g,是美国研究结果 30256 cfu/g 的两倍左右。
戴森用具体而详细的数据向我们普及了尘螨致敏原和霉菌无处不在,而且在某些地方密度还挺高,那么我们普通人对此可以做些什么?
对于床褥上的尘螨,戴森工程总监艾德里安诺•尼罗建议我们定期清理床上用品,去除尘螨的食物(人体皮屑)以及排泄物。至于清理的工具,尼罗当然首推他们自家的无绳手持吸尘器,其中 V6 系列就是这次被用来收集样本的机器。
(戴森工程总监艾德里安诺•尼罗)
新的 V6 系列手持吸尘器跟今年 1 月发布的 Fluffy DC74 很相似,最大的区别就是马达后滤网。据尼罗介绍,这个马达后滤网能有效去除 99.99% 小至 PM0.3 的微尘颗粒。
V6 手持吸尘器将数码马达升级到了第六代,尼罗称这个比手掌还小的数码马达,有着比 F1 赛车发动机转速还快的速度。
尼罗同时还提到了戴森吸尘器的可更换清洁头。戴森的清洁头通常由多种材质组成,碳纤维层可以吸除非常细微的颗粒,而且还抗静电。尼龙层则可以把深埋在地毯中的灰尘翻出来吸干净。除了细微的颗粒, V6 还可以吸除大至麦圈、硬币这样的颗粒物。
戴森今天还带来了一款新产品——加湿器。传统的加湿器往往会有容易滋生细菌的问题,据尼罗的介绍,戴森这款加湿器会先对水源进行三分钟的紫外线照射,然后再加湿,保证出来的空气是干净清洁的。